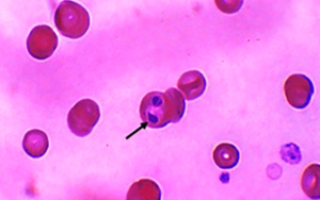

Бабезиоз
Многие паразитарные заболевания имеют широкое распространение среди сельскохозяйственных животных. Так как они вызывают значительный падеж скота, снижение удоев у коров и т. д., они имеют большое экономическое значение. Примером такого заболевания является бабезиоз крупного рогатого скота. Важно своевременно диагностировать его излечить животное во избежание значительных экономических потерь.
Возбудитель
Заболевание вызывается яшвотными паразитами, которые поражают кровь. Эти споровики проникают в организм и селятся в эритроцитах. С этим связаны некоторые трудности в лечении заболевания, так как все внутриклеточные паразиты лечатся достаточно сложно.
Бабезиоз под микроскопом
Эти споровики распространены достаточно широко. Существует множество их видов, все виды вызывают сходную симптоматику и имеют похожий патогенез. Распространены повсеместно, за исключением Антарктиды. В России максимальная численность паразитов зарегистрирована в Сибири.
Мнение врача:
Бабезиоз крупного рогатого скота протекает как острая инфекционная болезнь, вызываемая простейшими паразитами рода Babesia. Врачи отмечают, что основными симптомами заболевания у животных являются повышение температуры тела, слабость, анорексия, бледность слизистых оболочек, тахикардия и тахипноэ. В тяжелых случаях возможно появление желтухи и сильной анемии. Врачебная практика показывает, что бабезиоз может протекать в острой, подострой и хронической формах, что требует комплексного подхода к диагностике и лечению.

Пути передачи
Паразит переносится при укусах клещей. Наибольшую опасность имеют некоторые роды семейства Иксодовые. Споры клеща находятся в их слюне. При укусе такой клещ впрыскивает в кровь животного слюну, содержащую споры, после чего развивается заражение. Почти все виды пастбищных клещей представляют опасность в этом отношении.
В качестве профилактики применяются такие средства, как:
- Уничтожение на пастбищах грызунов, являющихся промежуточными хозяевами;
- Обеззараживание пастбищ и борьба с клещами;
- Периодическая обработка животных от клещей и от паразитов в целом.
В настоящий момент заболевание плохо изучено и не ясно, существуют ли иные пути передачи. Однако установлено, что соблюдение правил, перечисленных выше, почти полностью исключает вероятность распространения заражения в поголовье.
Предположительно, прямая передача от зараженной особи к здоровой происходить не может (за исключением случаев с переливанием крови).
Интересные факты
-
Бабезиоз крупного рогатого скота (КРС) является одним из самых распространенных и экономически значимых заболеваний, вызываемых простейшими кровепаразитами рода Babesia.
-
Бабезиоз передается через укусы клещей рода Ixodes, которые являются основными переносчиками инфекции. Клещи заражаются бабезиями, питаясь кровью инфицированных животных, и передают паразитов другим животным при последующих укусах.
-
Бабезиоз может протекать в острой, подострой и хронической формах. Острая форма характеризуется высокой температурой, анемией, желтухой и гемоглобинурией. Подострая форма протекает менее выраженно, но может привести к длительному истощению и снижению продуктивности животных. Хроническая форма характеризуется периодическими рецидивами заболевания и может привести к истощению и смерти животных.

Опасность для человека
Люди болеют бабезиозом. Однако, зачастую, его у них вызывают споровики других видов. Не ясно, могут ли приживаться споровики, поражающие КРС, в крови человека. Однако не рекомендуется употреблять мясо зараженных животных. Прямой передачи от животного человеку при контакте не существует.
Заболевание у людей встречается достаточно редко. Начиная с 1957 года, когда оно было впервые диагностировано в Югославии, в медицинской литературе описано всего около 100 случае данной болезни у людей. Однако при отсутствии грамотного и своевременного лечения, большинство из них имели летальный исход.
Опыт других людей
Бабезиоз крупного рогатого скота вызывает озабоченность у многих фермеров и специалистов в области животноводства. Люди отмечают, что бабезиоз может привести к серьезным потерям в скотоводстве из-за заболевания крупного рогатого скота. Они подчеркивают важность профилактических мер, таких как регулярное обследование животных, применение акарицидов и контроль за насекомыми-переносчиками. Многие также высказывают обеспокоенность осложнениями при лечении бабезиоза и призывают к более эффективным методам борьбы с этим заболеванием.
Симптомы
Симптоматика у КРС, обычно, острая. Болезнь имеет тенденцию к острому протеканию. В зависимости от вида клеща-переносчика, а также от вида и иммунитета животного инкубационный период может длиться от 8 до 15 дней. После этого возникает следующая симптоматика:
- Значительное повышение температуры тела (до 40-41 градуса);
- Общее угнетенное состояние, вялость;
- Нарушения аппетита;
- Снижение удоев в 4-5 раз;
- Появление в молоке горьковатого привкуса;
- Молоко становится желтоватым или красноватым, непригодным для употребления в пищу;
- В моче появляется кровь;
- Диарея чередуется с запором.
Острая стадия заканчивается примерно через неделю. Далее имеет место хроническое течение. Симптоматика в нем проявляется периодически и не так выраженно.
Истощение-один из симптомов бабезиоза
Даже развивается тяжелая анемия, интоксикация и аллергическая реакция. Закономерным последствием заболевания является почечная и печеночная недостаточность. Именно они, зачастую, и вызывают летальный исход. У КРС он составляет около 40%, тогда как у коз и овец гораздо выше, и может достигать 80%.
Диагностика
Диагностика проводится по анализу крови методом толстой капли. При нем проба окрашивается, и в ней обнаруживаются паразиты в эритроцитах. Иногда также применяется метод иммунофлуоресценции и иммуноферментный анализ. Если эти исследования недостаточно результативны (при небольшом количестве паразитов) может применяться биологический метод. Но, зачастую, он экономически нецелесообразен.
Часто диагностика проводится на основе симптоматики. Также учитывается эпидемиологическая обстановка. Важную роль в диагностике играет тщательный сбор анамнеза.
Лечение
Бабезиоз крупного рогатого скота при своевременном диагностировании достаточно успешно лечится. Важную роль в ходе лечения имеет правильное содержание животного. Его не выгоняют на пастбище, применяют только качественный корм – хорошее луговое сено или свежую траву. Можно давать свежее молоко, корнеплоды.
Медикаментозное лечение предполагает подкожное введение 2%-ного раствора гемоспоридина. Дозировка рассчитывается как 0,0005 г на 1 кг массы тела животного. Также можно лечить болезнь, вводя в мышцу азидин в дозировке 0,0035 г на 1 кг массы тела. Применяются они от 1 раза за двое суток до 1 раза в стуки. Обычно требуется 1-2 укола. Если выбрано лечение гемоспоридином, то перед ним животному нужно водить кофеин для нормализации работы сердца.

Частые вопросы
Какие симптомы у коровы после укуса клеща?
Слизистые анемичные, желтушного оттенка, заметны следы мелких кровоизлияний. Наблюдается аритмия. Животные часто мочатся, моча темного цвета. На 9–10 сутки при отсутствии лечения в большинстве случаев наступает летальный исход.
Как проявляется Бабезиоз?
Симптоматика бабезиоза внешне схожа с проявлением гриппа. Как правило, пациенты отмечают повышенную температуру тела, лихорадку, озноб, головные боли, мигрени, мышечные спазмы, тошноту, рвоту, запоры, поносы, нарушение аппетита, слабость.
Чем отличается Бабезиоз от пироплазмоза?
Бабезиоз (другое название – пироплазмоз) – это трансмиссивное кровепаразитарное заболевание. Это заражение внутриклеточными паразитами – бабезиями, которые попадают в кровь собаки при укусе клеща с его слюной. Сами клещи находятся в основном в траве не только в лесной местности, а также в городских парках и скверах.
Какие клетки поражаются при Пироплазмозе крупного рогатого скота?
Пироплазмоз (бабезиоз, техасская лихорадка, чихирь) – трансмиссивная болезнь животных, вызываемая паразитами эритроцитов крови – пироплазмами (бабезиями), сопровождающаяся высокой температурой, анемией и желтушностью слизистых оболочек, гемоглобинурией и расстройством деятельности многих органов и систем.
Полезные советы
СОВЕТ №1
При подозрении на бабезиоз крупного рогатого скота обратитесь к ветеринару для проведения диагностики и назначения соответствующего лечения.
СОВЕТ №2
Соблюдайте профилактические меры, такие как обработка животных от клещей и создание благоприятных условий для их содержания, чтобы предотвратить заболевание бабезиозом.